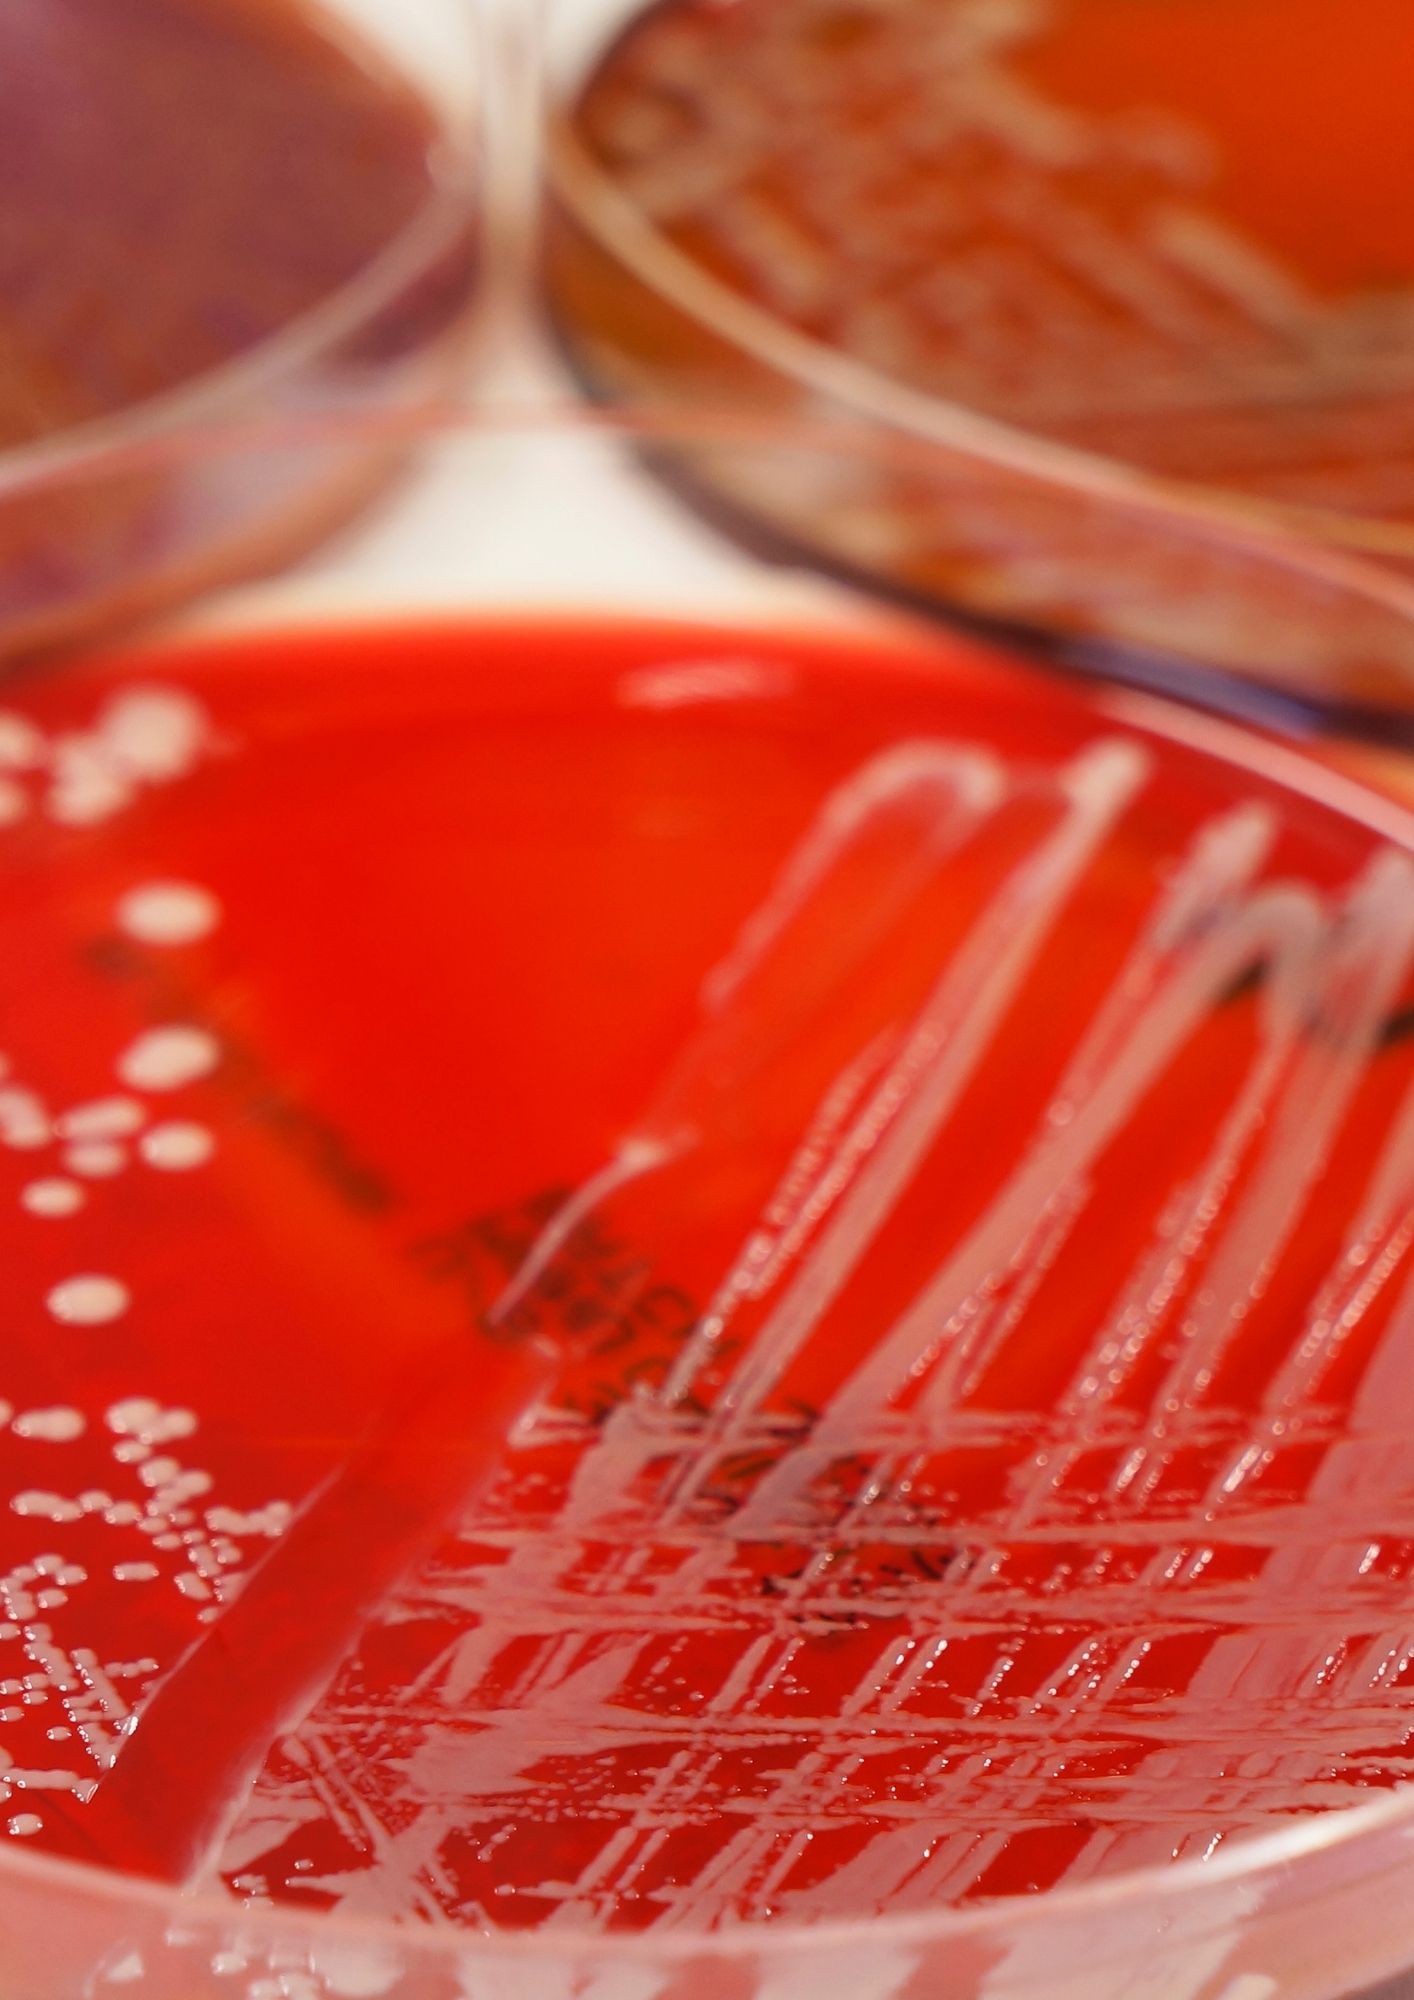
diseño sin título (20) diseño sin título (20)

Catálogos de análisis
Consulte todas las pruebas diagnósticas disponibles
por especie y área.
Explore nuestras pruebas diagnósticas diseñadas para facilitar la toma de decisiones clínicas y mejorar el abordaje sanitario de cada caso.

Hojas de solicitud
Descargue los formularios necesarios para el envío correcto de muestras.
Disponemos de hojas de solicitud estructuradas por especie y tipo de análisis que permiten recoger toda la información clínica relevante y agilizar el diagnóstico laboratorial.
Envío de muestras
Proceso sencillo y guiado paso a paso.
Desde la preparación de la muestra hasta la recogida y el envío al laboratorio, le guiamos en todo el proceso. Consulte las instrucciones detalladas para asegurar una correcta manipulación, embalaje y documentación.


Protocolos de muestreo
La calidad del diagnóstico comienza en el muestreo.
Consulte los protocolos detallados para cada especie y categoría clínica. Le indicamos cómo realizar la toma, el acondicionamiento y el envío de muestras para optimizar la fiabilidad de los análisis.
Nuestros KITS
Simplificamos la recogida de muestras.
Soluciones estandarizadas para la recogida de muestras en campo, diseñadas para mantener la integridad de la muestra y facilitar su procesamiento en laboratorio.


